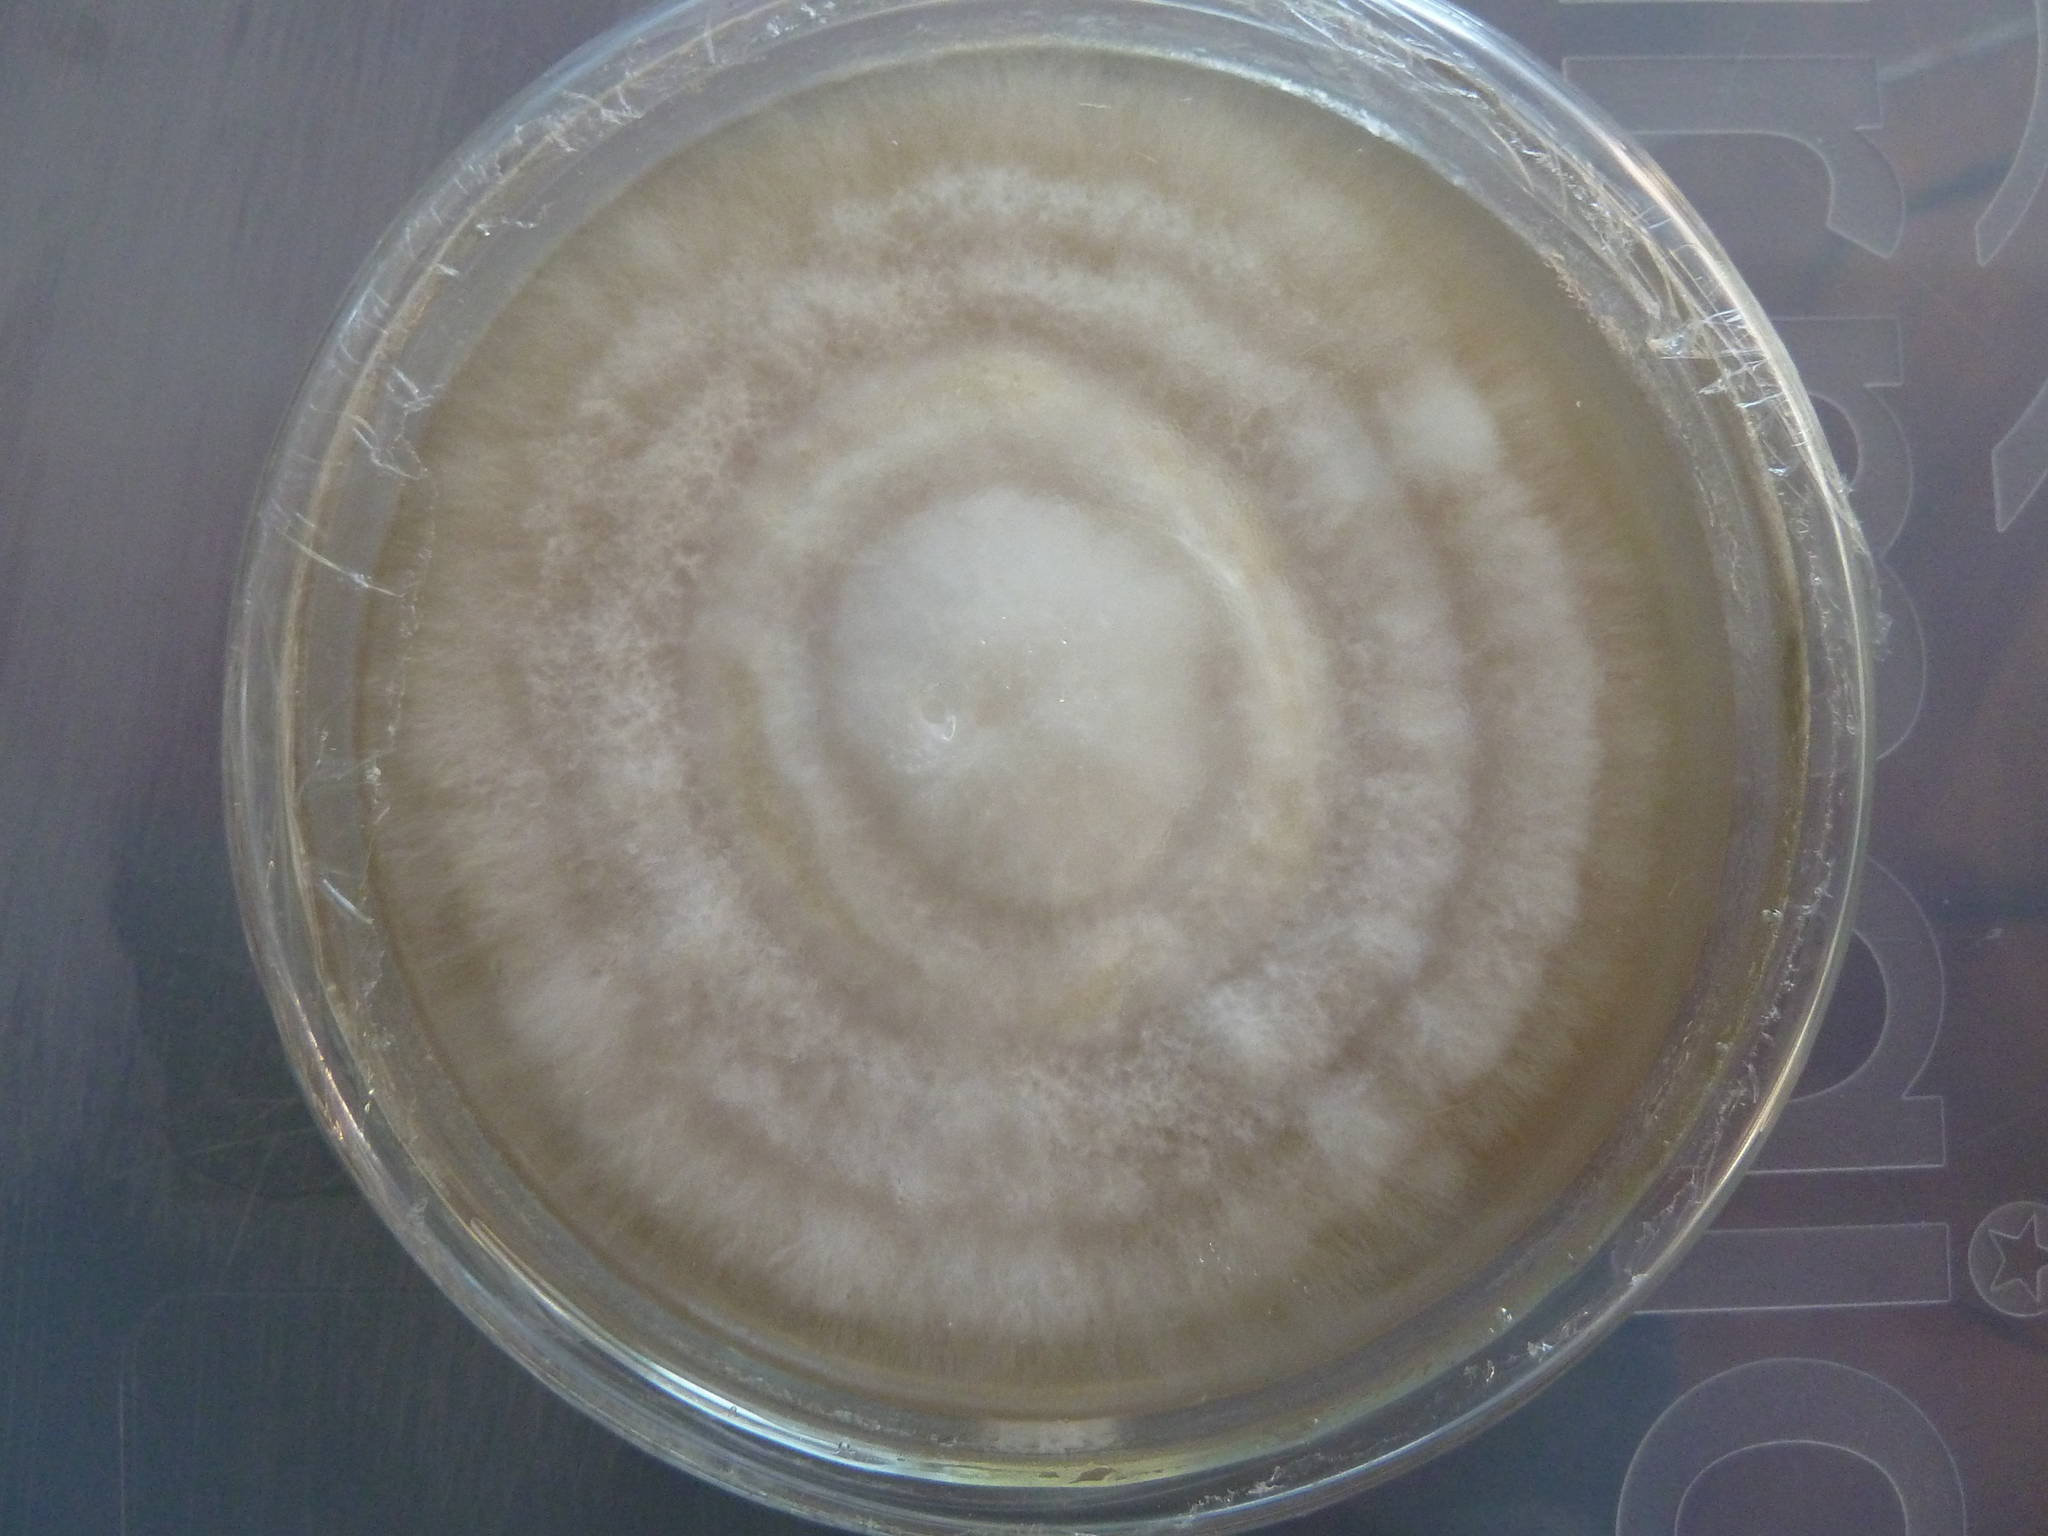

Membuat Bibit F0 Jamur Tiram Putih di Media PDA dengan alat sederhana
Bibit F0 merupakan bibit indukan atau kultur murni jamur yang ditumbuhkan pada media PDA( Potatoes Dextrose Agar) . Jadi langkah pertama yang kita buat dahulu adalah media PDA. berikut bahan- bahan, perlengkapan serta peralatan yang dibutuhkan :
Bahan :
1. Agar- agar sebanyak 20 (bisa merk apa saja, seleksi yang tidak bercorak atau dengan warna netral)
2. Air bersih 1000 ml. Air dari sumur dapat dipakai namun lebih bagus air aquades( tidak wajib)
3. Kentang yang telah dikupas 300 gr
Alat :
1. Kompor
2. Panci
3. Pisau
4. Timbangan tabung ukur
5. Sendok
6. Cangkir petri secukupnya
7. Autoclave ataupun tipe murahnya panci presto
Metode pembuatannya semacam berikut:
- Kupas kentang serta timbang sebanyak 200 gr setelah itu potong dadu dimensi 1×1 centimeter, kemudian rebus dengan air 1000ml hingga nampak sarinya keluar. Setelah itu angkat kentangnya dan saring sehingga mendapatkan 500 atau lebih ml dari air yang di rebus tadi. jika air rebusan melebihi 700ml artinya sari kentang masih belum dikatakan banyak.
- Tambahkan agar- agar 20 gr dan Dextrose 20gr. kemudian masukkan lagi ke dalam panci sembari terus diaduk.
- Setelah mendidih, masukkan PDA yang masih cair ke dalam cangkir petri, tabung reaksi/pyrex ataupun botol kaca berwarna bening biasa.
- Setelah PDA mengental. Tutup cangkir petri serta masukkan cangkir petri ke dalam autoclave ataupun panci presto, serta panaskan lagi sepanjang dengan suhu 121° c dengan tekanan 21 PSI
- Setelah selesai, biarkan cangkir petri dingin kembali serta jangan dibuka, jika anda menggunakan botol biasa letakan botol dalam keadaan miring dan biarkan dingin serta mengental kembali, hal ini di lakukan agar mendapatkan permukaan media yang luas pada botol biasa
Catatan Penting : Proses memasak PDA dengan autoclave ataupun panci presto adalah proses sterilisasi yang bertujuan untuk membunuh bakteri atau pengganggu yang terdapat pada media PDA. Jika PDA rusak akibat bakteri (terlihat bercak pada media), PDA tersebut tidak dapat dipakai serta wajib mengulangi proses ini dari awal.
Setelah PDA dibuat, selanjutnya adalah proses pembibitan F0 atau Inokulasi. Berikut bahan serta perlengkapan yang dibutuhkan:
- Jamur tiram yang masih segar
- Laminar simpel untuk tempat melaksanakan proses pembibitan
- Spirtus pembakar bunsen
- Cuter steril
- Alkohol 95 persen
- Pinset berbahan dasar stainless
Metode Membuat Bibit F0 Jamur Tiram
Baca Juga : Cara Membuat Alat Steam atau Sterilisasi Baglog
Pembuatan bibit F0 wajib dicoba di tempat yang steril. Instansi- instansi dengan modal besar umumnya memakai laminar air flow yang harga per unitnya mencapai puluhan juta rupiah. Untuk Pemula yang masih belajar. Dapat pula memakai akuarium bekas yang sudah di bersihkan. Alkohol, spiritus serta pembakar bunsen diperlukan untuk membersihkan kotak pembibitan serta perlengkapan yang dipakai.
Langkah- langkahnya adalah sebagai berikut:
- Sterilkan laminar dengan api bunsen kurang lebih selama 15 menit ataupun bisa pula dicoba dengan menghidupkan lampu UV yang dipasang tadinya selama 15 menit.
- Semprot tangan serta perlengkapan dengan alcohol 70%
- Masukan perlengkapan peralatan ke dalam laminar
- Sterilisasi cutter dengan api bunsen diulang beberapa kali
- Sterilisasi pinset 5- 10 detik diulang beberapa kali
- Siapkan PDA yang sudah dingin tadi, siapkan jamur, sterilkan cutter saat sebelum penyayatan serta sayat tangkai dasar sejauh 0, 5 centimeter persegi secara searah
- Sterilkan salah satu sisi cangkir petri, buka sedikit, setelah itu langsung masukkan sayatan batang dasar jamur ke dalam cangkir petri. lakukan ini didekat api bunsen serta setelah itu tutup kembali.
- Teruskan sebanyak media PDA yang telah anda buat.
- Simpan cangkir petri yang telah berisi potongan jamur ke dalam penyimpanan yang gelap serta hangat.
- Tunggu miselium keluar dari potongan jamur serta penuhi seluruh permukanan PDA
- Bila miselium telah menutupi permukaan PDA, hingga bibit F0 telah siap buat dilanjutkan ke bibit F1
Metode Membuat Bibit F0 Jamur Tiram
Proses pembuatan bibit F0 jamur tiram memakan waktu yang berda- beda, bergantung pada wadah media PDA. Bila memakai wadah cangkir petri standar, waktu yang diperlukan buat miselium berkembang menutupi seluruh permukaan PDA kurang lebih 2 minggu atau lebih.